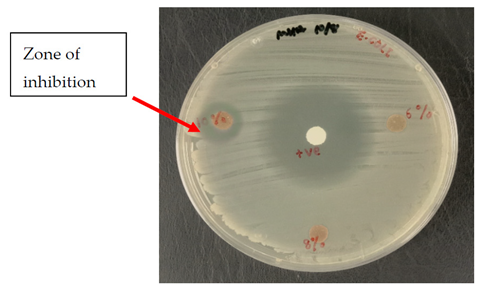
Polymers 13 03928 i001
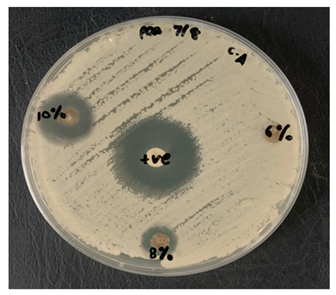
Polymers 13 03928 i003

Effect of Silver Nanopowder on Mechanical, Thermal and Antimicrobial Properties of Kenaf/HDPE Composites
Abstract
:1. Introduction
2. Materials and Methods
2.1. Materials
2.2. Sample Preparation
2.3. Thermal Analysis
2.3.1. Thermogravimetric Analysis (TGA)
2.3.2. Differential Scanning Calorimetry (DSC)
2.4. Antimicrobial Analysis
3. Results and Discussion
3.1. Tensile Properties
3.2. Thermal Properties
3.2.1. Thermogravimetric Analysis (TGA)
3.2.2. Differential Scanning Calorimetry (DSC)
3.3. Antimicrobial Testing
4. Conclusions
Author Contributions
Funding
Institutional Review Board Statement
Informed Consent Statement
Data Availability Statement
Acknowledgments
Conflicts of Interest
References
- Mosiewicki, M.A.; Aranguren, M.I. A short review on novel biocomposites based on plant oil precursors. Eur. Polym. J. 2013, 49, 1243–1256. [Google Scholar] [CrossRef] [Green Version]
- Wegner, T.H.; Jones, E.P. A fundamental review of the relationships between nanotechnology and lignocellulosic biomass. Nanosci. Technol. Renew. Biomater. 2009, 1, 1–41. [Google Scholar]
- Zhang, X.F.; Liu, Z.G.; Shen, W.; Gurunathan, S. Silver nanoparticles: Synthesis, characterization, properties, applications, and therapeutic approaches. Int. J. Mol. Sci. 2016, 17, 1534. [Google Scholar] [CrossRef] [PubMed]
- Rhim, J.W.; Wang, L.F.; Hong, S.I. Preparation and characterization of agar/silver nanoparticles composite films with antimicrobial activity. Food Hydrocoll. 2013, 33, 327–335. [Google Scholar] [CrossRef]
- Shankar, S.; Jaiswal, L.; Aparna, R.S.L.; Prasad, R.G.S.V. Synthesis, characterization, in vitro biocompatibility, and antimicrobial activity of gold, silver and gold silver alloy nanoparticles prepared from Lansium domesticum fruit peel extract. Mater. Lett. 2014, 137, 73–75. [Google Scholar] [CrossRef]
- Chernousova, S.; Epple, M. Silver as Antibacterial Agent: Ion, Nanoparticle, and Metal. Angew. Chem. Int. Ed. 2013, 52, 1636–1653. [Google Scholar] [CrossRef]
- Saba, N.; Tahir, P.M.; Jawaid, M. A review on potentiality of nano filler/natural fiber filled polymer hybrid composites. Polymers 2014, 6, 2247–2273. [Google Scholar] [CrossRef]
- Nurani, S.J.; Saha, C.K. Silver Nanoparticles Synthesis, Properties, Applications and Future Perspectives: A Short Review Silver Nanoparticles Synthesis, Properties, Applications and Future Perspectives: A Short Review Sharif Masnad Hossain Sunny. IOSR J. Electr. Electron. Eng. 2015, 10, 117–126. [Google Scholar]
- Elnour, K.M.M.A.; Alwarthan, A.; Ammar, R.A.A. Synthesis and applications of silver nanoparticles. Arab. J. Chem. 2010, 3, 135–140. [Google Scholar]
- Aji, I.S.; Sapuan, S.M.; Zainudin, E.S.; Abdan, K. Kenaf fibres as reinforcement for polymeric composites: A review. Int. J. Mech. Mater. Eng. 2009, 4, 239–1248. [Google Scholar]
- Anuar, H.; Zuraida, A. Improvement in mechanical properties of reinforced thermoplastic elastomer composite with kenaf bast fibre. Compos. Part B Eng. 2011, 42, 462–465. [Google Scholar] [CrossRef]
- Ali, M.R.; Salit, M.S.; Jawaid, M.; Mansur, M.R.; Manap, M.F.A. Polyurethane Polymers Composites and Nanocomposites; Elsevier: Amsterdam, The Netherlands, 2018; pp. 521–546. [Google Scholar]
- Radzi, A.M.; Sapuan, S.M.; Jawaid, M.; Mansor, M.R. Influence of fibre contents on mechanical and thermal properties of roselle fibre reinforced polyurethane composites. Fibers Polym. 2017, 18, 1353–1358. [Google Scholar] [CrossRef]
- Kumar, V.; Kumari, M. Processing and characterization of natural cellulose fibers/thermoset polymer composites. Carbohydr. Polym. 2014, 109, 102–117. [Google Scholar]
- Prithivirajan, R.; Jayabal, S.; Bharathiraja, G. Bio-based composites from waste agricultural residues: Mechanical and morphological properties. Cellul. Chem. Technol. 2015, 49, 65–68. [Google Scholar]
- Radzi, A.M.; Sapuan, S.M.; Jawaid, M.; Mansor, M.R. Water absorption, thickness swelling and thermal properties of roselle/sugar palm fibre reinforced thermoplastic polyurethane hybrid composites. J. Mater. Res. Technol. 2019, 8, 3988–3994. [Google Scholar] [CrossRef]
- Radzi, A.M.; Sapuan, S.M.; Jawaid, M.; Mansor, M.R. Effect of Alkaline Treatment on Mechanical, Physical and Thermal Properties of Roselle/Sugar Palm Fiber Reinforced Thermoplastic Polyurethane Hybrid Composites. Fibers Polym. 2019, 20, 847–855. [Google Scholar] [CrossRef]
- Venkateshwaran, N.; ElayaPerumal, A. Mechanical and water absorption properties of woven jute/banana hybrid composites. Fibers Polym. 2012, 13, 907–914. [Google Scholar] [CrossRef]
- Abdallah, F.B.; Cheikh, R.B.; Baklouti, M.; Denchev, Z.; Cunha, A.M. Effect of surface treatment in cork reinforced composites. J. Polym. Res. 2010, 17, 519–528. [Google Scholar] [CrossRef]
- Shamsuri, A.A.; Azid, M.K.A.; Ariff, A.H.M.; Sudari, A.K. Influence of surface treatment on tensile properties of low-density polyethylene/cellulose woven biocomposites: A preliminary study. Polymers. 2014, 6, 2345–2356. [Google Scholar] [CrossRef] [Green Version]
- Joshi, S.V.; Drzal, L.T.; Mohanty, A.K.; Arora, S. Are natural fiber composites environmentally superior to glass fiber reinforced composites? Compos. Part A Appl. Sci. Manuf. 2004, 35, 371–376. [Google Scholar] [CrossRef]
- Yahaya, R.; Sapuan, S.M.; Jawaid, M.; Leman, Z.; Zainudin, E.S. Effect of layering sequence and chemical treatment on the mechanical properties of woven kenaf-aramid hybrid laminated composites. Mater. Des. 2015, 67, 173–179. [Google Scholar] [CrossRef]
- Nishino, T.; Hirao, K.; Kotera, M.; Nakamae, K.; Inagaki, H. Kenaf reinforced biodegradable composite. Compos. Sci. Technol. 2003, 63, 1281–1286. [Google Scholar] [CrossRef]
- El-shekeil, Y.A.; Sapuan, S.M.; Abdan, K.; Zainudin, E.S. Influence of fiber content on the mechanical and thermal properties of Kenaf fiber reinforced thermoplastic polyurethane composites. Mater. Des. 2012, 40, 299–303. [Google Scholar] [CrossRef]
- Zampaloni, M.; Pourboghrat, F. Kenaf natural fiber reinforced polypropylene composites: A discussion on manufacturing problems and solutions. Compos. Part A Appl. Sci. Manuf. 2007, 38, 1569–1580. [Google Scholar] [CrossRef]
- Azammi, A.M.N.; Sapuan, S.M.; Ishak, M.R.; Sultan, M.T.H. Mechanical and Thermal Properties of Kenaf Reinforced Thermoplastic Polyurethane (TPU)-Natural Rubber (NR) Composites. Fibers Polym. 2018, 19, 446–451. [Google Scholar] [CrossRef] [Green Version]
- Yahaya, R.; Sapuan, S.M.; Jawaid, M.; Leman, Z.; Zainudin, E.S. Mechanical performance of woven kenaf-Kevlar hybrid composites. J. Reinf. Plast. Compos. 2014, 33, 2242–2254. [Google Scholar] [CrossRef]
- Shamsuri, A.A.; Zolkepli, M.N.M.; Ariff, A.H.M.; Sudari, A.K.; Zarin, M.A. A Preliminary Investigation on Processing, Mechanical and Thermal Properties of Polyethylene/Kenaf Biocomposites with Dolomite Added as Secondary Filler. J. Compos. 2015, 2015, 1–7. [Google Scholar] [CrossRef] [Green Version]
- Dhawan, V.; Singh, S.; Singh, I. Effect of Natural Fillers on Mechanical Properties of GFRP Composites. J. Compos. 2013, 1–8. [Google Scholar] [CrossRef] [Green Version]
- ASTM. Standard Test Method for Compositional Analysis by Thermogravimetry 1. ASTM Int. 2015, 8, 6. [Google Scholar]
- Barud, H.S.; Regiani, T.; Marques, R.F.C.; Lustri, W.R.; Messaddeq, Y.; Ribeiro, S.J.L. Antimicrobial bacterial cellulose-silver nanoparticles composite membranes. J. Nanomater. 2011, 2011, 721631. [Google Scholar] [CrossRef] [Green Version]
- Radzi, A.M.; Sapuan, S.M.; Jawaid, M.; Mansor, M.R. Mechanical and Thermal Performances of Roselle Fiber-Reinforced Thermoplastic Polyurethane Composites. Polym. Plast. Technol. Eng. 2018, 57, 601–608. [Google Scholar] [CrossRef]
- Sapiai, N.; Jumahat, A.; Mahmud, J. Flexural and Tensile Properties of Kenaf/Glass Fibres Hybrid Composites. J. Teknol. 2015, 3, 115–120. [Google Scholar]
- Zakaria, M.R.; Akil, H.M.; Kudus, M.H.A.; Kadarman, A.H. Improving flexural and dielectric properties of MWCNT/epoxy nanocomposites by introducing advanced hybrid filler system. Compos. Struct. 2015, 132, 50–64. [Google Scholar] [CrossRef]
- Finnigan, B.; Martin, D.; Halley, P.; Truss, R.; Campbell, K. Morphology and properties of thermoplastic polyurethane nanocomposites incorporating hydrophilic layered silicates. Polymer 2004, 45, 2249–2260. [Google Scholar] [CrossRef]
- Xie, W.; Gao, Z.; Pan, W.P.; Hunter, D.; Singh, A.; Vaia, R. Thermal degradation chemistry of alkyl quaternary ammonium Montmorillonite. Chem. Mater. 2001, 13, 2979–2990. [Google Scholar] [CrossRef]
- Kian, L.K.; Jawaid, M.; Ariffin, H.; Karim, Z.; Sultan, M.T.H. Morphological, physico-chemical, and thermal properties of cellulose nanowhiskers from roselle fibers. Cellulose 2019, 26, 6599–6613. [Google Scholar] [CrossRef]
- Chee, S.S.; Jawaid, M.; Sultan, M.T.H. Thermal Stability and Dynamic Mechanical Properties of Kenaf/Bamboo Fibre Reinforced Epoxy Composites. BioResources 2017, 12, 7118–7132. [Google Scholar]
- Asim, M.; Paridah, M.T.; Saba, N. Thermal, physical properties and flammability of silane treated kenaf/pineapple leaf fibres phenolic hybrid composites. Compos. Struct. 2018, 202, 1330–1338. [Google Scholar] [CrossRef]
- Khalil, H.A.; Suraya, N.; Atiqah, N.; Jawaid, M.; Hassan, A. Mechanical and thermal properties of chemical treated kenaf fibres reinforced polyester composites. J. Compos. Mater. 2013, 47, 3343–3350. [Google Scholar] [CrossRef]
- El-Shekeil, Y.A.; Sapuan, S.M.; Abdan, K.; Zainudin, E.S.; Al-SHUJA’A, O.M. Effect of pMDI isocyanate additive on mechanical and thermal properties of Kenaf fibre reinforced thermoplastic polyurethane composites Y. Bull. Mater. Sci. 2012, 35, 1151–1155. [Google Scholar]
- Shankar, S.; Wang, L.F.; Rhim, J.W. Preparations and characterization of alginate/silver composite films: Effect of types of silver particles. Carbohydr. Polym. 2016, 146, 208–216. [Google Scholar] [CrossRef]
- Sahari, J.; Sapuan, S.M.; Zainudin, E.S.; Maleque, M.A. Physico-chemical and thermal properties of starch derived from sugar palm tree (Arenga pinnata). Asian J. Chem. 2014, 26, 955–959. [Google Scholar] [CrossRef]
- Volova, T.G.; Shumilova, A.A.; Shidlovskiy, I.P. Antibacterial properties of films of cellulose composites with silver nanoparticles and antibiotics. Polym. Test. 2018, 65, 54–68. [Google Scholar] [CrossRef] [Green Version]
- Yu, H.; Sun, B.; Zhang, D.; Chen, G.; Yang, X.; Yao, J. Reinforcement of biodegradable poly(3-hydroxybutyrate-co-3-hydroxyvalerate) with cellulose nanocrystal/silver nanohybrids as bifunctional nanofillers. J. Mater. Chem. B. 2014, 2, 8479–8489. [Google Scholar] [CrossRef] [PubMed]
- Yu, H.Y.; Yang, X.Y.; Lu, F.F.; Chen, G.Y.; Yao, J.M. Fabrication of multifunctional cellulose nanocrystals/poly(lactic acid) nanocomposites with silver nanoparticles by spraying method. Carbohydr. Polym. 2016, 140, 209–219. [Google Scholar] [CrossRef] [PubMed]
- Jumaidin, R.; Sapuan, S.M.; Jawaid, M.; Ishak, M.R.; Sahari, J. Characteristics of Thermoplastic Sugar Palm Starch/Agar Blend: Thermal, Tensile, and Physical Properties. Int. J. Biol. Macromol. 2016, 89, 575–581. [Google Scholar] [CrossRef] [PubMed]
- Syafiq, R.; Sapuan, S.M.; Zuhri, M.R.M. Antimicrobial activities of starch-based biopolymers and biocomposites incorporated with plant essential oils: A review. Polymers 2020, 12, 2403. [Google Scholar] [CrossRef] [PubMed]
- Veranitisagul, C.; Wattanathana, W.; Wannapaiboon, S.; Hanlumyuang, Y.; Sukthavorn, K.; Nootsuwan, N.; Chotiwan, S.; Phuthong, W.; Jongrungruangchok, S.; Laobuthee, A. Antimicrobial, conductive, and mechanical properties of AgCB/PBS composite system. J. Chem. 2019. [Google Scholar] [CrossRef]
- Priyadarshini, S.; Gopinath, V.; Priyadharsshini, N.M.; MubarakAli, D.; Velusamy, P. Synthesis of anisotropic silver nanoparticles using novel strain, Bacillus flexus and its biomedical application. Colloids Surf. B 2013, 102, 232–237. [Google Scholar] [CrossRef] [PubMed]









| AgNPs (%) | Maximum Degradation Temperature (℃) | Weight Loss (%) | Char at 600 °C (wt%) |
|---|---|---|---|
| 0 | 472 | 80.45 | 3.27 |
| 2 | 479 | 80.42 | 6.02 |
| 4 | 493 | 80.40 | 6.97 |
| 6 | 494 | 80.43 | 5.47 |
| 8 | 495 | 80.50 | 6.77 |
| 10 | 496 | 80.41 | 12.96 |
| AgNPs (wt %) | Tm (Onset Value) (°C) | Tm (Midpoint Value) (°C) |
|---|---|---|
| 0 | 120.76 | 129.97 |
| 2 | 120.90 | 129.98 |
| 4 | 121.17 | 132.20 |
| 6 | 121.90 | 132.75 |
| 8 | 122.78 | 133.45 |
| 10 | 128.53 | 133.83 |
| Concentration of AgNPs (wt %) | Target Microbes | ||
|---|---|---|---|
| Escherichia Coli UPMC 25922 | Pseudomonas Aeruginosa ATCC 15442 | Candida Albicans ATCC 90028 | |
| 0 | − | − | − |
| 2 | − | − | − |
| 4 | − | − | − |
| 6 | − | − | − |
| 8 | − | − | + |
| 10 | + | + | + |
| Microbes Concentration of AgNPs (wt%) | Inhibition Zone (mm) | |
|---|---|---|
| Escherichia Coli UPMC 25922 | Pseudomonas Aeruginosa ATCC 15442 | |
| 10 | 12.2 | 14.3 |
| Microbes Concentration of AgNPs (wt%) | Inhibition Zone (mm) |
|---|---|
| Candida Albicans ATCC 90028 | |
| 8 | 6 |
| 10 | 17.5 |
| Microbes | Images |
|---|---|
| Escherichia coli UPMC 25922 | |
| Pseudomonas aeruginosa ATCC 15442 |  |
| Candida albicans ATCC 90028 | |
Publisher’s Note: MDPI stays neutral with regard to jurisdictional claims in published maps and institutional affiliations. |
© 2021 by the authors. Licensee MDPI, Basel, Switzerland. This article is an open access article distributed under the terms and conditions of the Creative Commons Attribution (CC BY) license (https://creativecommons.org/licenses/by/4.0/).
Share and Cite
Sanmuham, V.; Sultan, M.T.H.; Radzi, A.M.; Shamsuri, A.A.; Md Shah, A.U.; Safri, S.N.A.; Basri, A.A. Effect of Silver Nanopowder on Mechanical, Thermal and Antimicrobial Properties of Kenaf/HDPE Composites. Polymers 2021, 13, 3928. https://doi.org/10.3390/polym13223928
Sanmuham V, Sultan MTH, Radzi AM, Shamsuri AA, Md Shah AU, Safri SNA, Basri AA. Effect of Silver Nanopowder on Mechanical, Thermal and Antimicrobial Properties of Kenaf/HDPE Composites. Polymers. 2021; 13(22):3928. https://doi.org/10.3390/polym13223928
Chicago/Turabian StyleSanmuham, Vikneswari, Mohamed Thariq Hameed Sultan, A. M. Radzi, Ahmad Adlie Shamsuri, Ain Umaira Md Shah, Syafiqah Nur Azrie Safri, and Adi Azriff Basri. 2021. "Effect of Silver Nanopowder on Mechanical, Thermal and Antimicrobial Properties of Kenaf/HDPE Composites" Polymers 13, no. 22: 3928. https://doi.org/10.3390/polym13223928
APA StyleSanmuham, V., Sultan, M. T. H., Radzi, A. M., Shamsuri, A. A., Md Shah, A. U., Safri, S. N. A., & Basri, A. A. (2021). Effect of Silver Nanopowder on Mechanical, Thermal and Antimicrobial Properties of Kenaf/HDPE Composites. Polymers, 13(22), 3928. https://doi.org/10.3390/polym13223928










